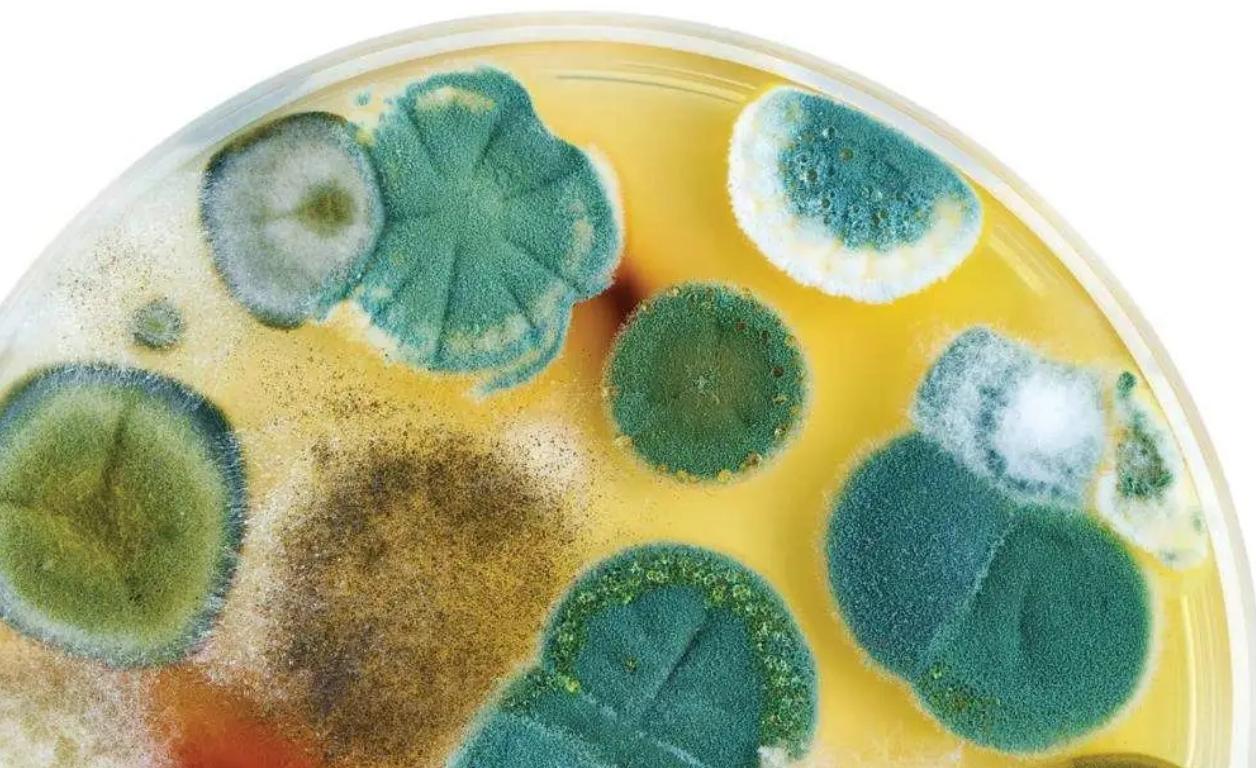
国际空间站出现轻微空气泄漏,国际空间站空气泄漏危害

如今国际空间站已经服役20多年,即将到寿命期限,预计将在2024年退役,但美国却不希望其这么早就退役,如今正想方设法延长其使用期限。而延长寿命的唯一办法就是继续投钱维护,只可惜随着其出现的问题越来越多,各国已经不想继续维护。不久前,其刚被曝出舱段出现裂缝,如今又出现一个新问题,而这显然不是短时间就能解决的问题。

最近俄罗斯宇航员在日常维修时发现空气中的霉菌含量竟然超标,正常标准下每平方米的霉菌含量应该低于100个单位,但国际空间站空气中的含量已经达到110个单位。霉菌相信大家都不陌生,其具备很强的繁殖能力,对人体来说是伤害力最强的一种真菌。长时间呼吸含有大量霉菌的空气会严重影响人体呼吸道与肺部,使人体免疫力降低,如今其出现在空间站中,宇航员们的身体健康告急。
太空中也会有霉菌?空间站舱段“长毛”,霉菌太空生存无压力。一般菌类微生物只会出现在潮湿、不透风的环境中,如今却出现在舱段内部,看来宇航员的生活环境很符合其生存环境,但这却不是个好消息。这类霉菌很难彻底清除,2016年时也曾出现过类似情况,为此宇航员们每天都要花费大量时间清洗舱体内部,防止其继续破坏。而远离地球、医疗物资十分匮乏的太空中,即便是简单的感染也会带来致命影响。

而这些霉菌的生命力超乎人们想象,科学家们曾对其进行过抗辐射能力测试,用各种辐射来照射其孢子,结果发现其生命力远超想象。就拿出现在国际空间站中的霉菌来说,其可以承受的辐射量达到人类致死量的200倍,因此其在太空中才能正常存活。也就是说,霉菌比人类还能适应太空环境,而其是否会因为辐射发生变异,目前科学家仍无定论。

因此对于霉菌的出现绝对不能掉以轻心,同时这也给“天宫”敲响了警钟。作为国际空间站的“接班者”,其未来将成为全球唯一在轨空间站,各国都已积极伸来橄榄枝。在同样的环境下,既然国际空间站舱段都会“发霉”,那么其想必也无法避免。为此在日常活动中应当做好祛湿、杀菌等工作,防止霉菌在悄无声息之中遍布舱段内壁,对宇航员的身体健康造成影响。
(文/席乐)